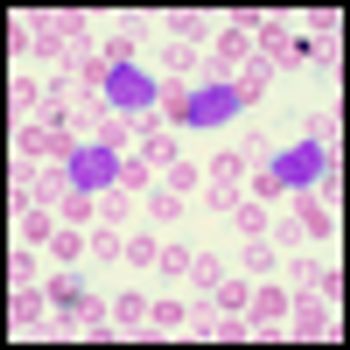

Early consolidation therapy with brentuximab vedotin after autologous stem cell transplant improved progression-free survival of patients with Hodgkin lymphoma.

Early consolidation therapy with brentuximab vedotin after autologous stem cell transplant improved progression-free survival of patients with Hodgkin lymphoma.

A single cycle of blinatumomab resulted in complete minimal residual disease response in 78% of patients with acute lymphoblastic leukemia.

An oral inhibitor of isocitrate dehydrogenase 2 (IDH2), AG-221, has shown activity and potentially durable remissions in patients with acute myeloid leukemia.

In this video from the 2014 ASH Annual Meeting, Dr. Röllig discusses the results of the SORAML trial that tested sorafenib in patients with acute myeloid leukemia.

In this video from the 2014 ASH Meeting, Dr. Grupp discusses data from a trial using CAR T-cell therapy in children and young adults with relapsed, treatment-resistant ALL.

Adding carfilzomib to lenalidomide and dexamethasone resulted in a higher PFS and better overall quality of life for relapsed multiple myeloma patients.

The anti–PD-1 (programmed death 1) antibody nivolumab has shown activity in patients with hematologic cancers who have failed three or more prior therapies.

The anti-PD-1 drug pembrolizumab demonstrated promising anti-tumor activity in patients with heavily pretreated classic Hodgkin lymphoma.

Sorafenib proved to have a high level of efficacy in younger acute myeloid leukemia patients, improving both event- and relapse-free survival over placebo.

T-lymphoblastic leukemia (T-ALL) should no longer be considered a poor-risk disease in the pediatric population, according to data presented at ASH.

In this podcast from the 2014 American Society of Hematology Annual Meeting, we discuss some of the new developments in multiple myeloma.

Ahead of the 2014 ASH Annual Meeting & Exhibition we discuss current treatment strategies for elderly patients with acute myeloid leukemia.

A phase III trial of idelalisib plus rituximab in patients with previously treated chronic lymphocytic leukemia found that the combo improved progression-free and overall survival, according to results presented at the 2013 ASH meeting.

In a study presented at the 2013 ASH meeting, researchers showed evidence that p53 mutations are already present in patients who develop treatment-related MDS and AML, results which could help identify high-risk patients prior to cytotoxic therapy.

Treatment with gemtuzumab ozogamicin improved the event-free survival in children and adolescents with acute myeloid leukemia by reducing the risk of relapse among those able to achieve remission, according to trial results presented at the 2013 ASH meeting.

Patients aged 70 years or older had similar survival outcomes compared to their younger counterparts when undergoing nonmyeloablative, related haploidentical bone marrow or peripheral blood stem cell transplants for the treatment of hematologic malignancies, according to the results of a study presented at the 2013 ASH meeting.

The combination of lenalidomide plus dexamethasone demonstrated an improvement in both response rate and survival in newly diagnosed multiple myeloma patients not eligible for a stem cell transplant, according to data presented at the 2013 ASH meeting.

Patients with the rare and potentially deadly multicentric Castleman disease were able to achieve durable tumor and symptomatic response when assigned to treatment with the monoclonal antibody siltuximab, according to data presented at the 2013 ASH meeting.

In a late-breaking abstract presentation, Thorsten Klampfl, PhD, of the CeMM Research Center for Molecular Medicine of the Austrian Academy of Sciences in Vienna, presented data from a whole exome study of primary myelofibrosis patients, identifying a new specific molecular mutation

In a 12-patient multiple myeloma pilot study, researchers demonstrated that anti-CD3 and anti-CD20 bispecific antibody (CD20Bi) activated both cellular and humoral anti-myeloma immunity that was detectable after patients received an autologous stem cell transplant.

In this video, Dr. Mikhael discusses the current treatment paradigm for multiple myeloma and highlights some of the new agents in development.

Patients of non-white northern European descent have better access to transplant than ever before due to access to cord blood and haploidentical transplants, a new study presented at the ASH annual meeting indicated.

In a front-line trial of older patients with newly diagnosed chronic lymphocytic leukemia, obinutuzumab topped rituximab, demonstrating improvements in response rate and progression-free survival, according to results presented at the ASH annual meeting.

As part of our coverage for the 2013 American Society of Hematology Annual Meeting and Exposition, we discuss some of the research that will be highlighted during this year’s meeting.

A combination of all-trans retinoic acid (ATRA) and arsenic trioxide resulted in outcomes “at least not inferior” to those achieved when ATRA was used in combination with idarubicin chemotherapy in newly diagnosed patients with non–high-risk, acute promyelocytic leukemia.

Preliminary findings presented at ASH suggest a “favorable emerging clinical profile” for once weekly administration of MLN9708 in combination with lenalidomide and dexamethasone in patients with newly diagnosed multiple myeloma.

The combination of rituximab and the novel immunotherapy pidilizumab (CT-011) is both active and well tolerated in follicular lymphoma patients according to results of a phase II trial presented at ASH.

ARRY-520, a novel selective kinesin spindle protein (KSP) inhibitor showed promising clinical activity both alone and combined with low-dose dexamethasone in a phase II clinical trial in patients with relapsed and refractory multiple myeloma.

The targeted agent ibrutinib has shown a high response rate in both treatment-naive and previously treated, relapsed, refractory chronic lymphocytic leukemia (CLL) patients older than 65.
Relapsed or refractory chronic lymphocytic leukemia and acute lymphoblastic leukemia patients have shown durable responses of almost 2 years to a novel T-cell engineering technique developed at the University of Pennsylvania Perelman School of Medicine in Philadelphia.